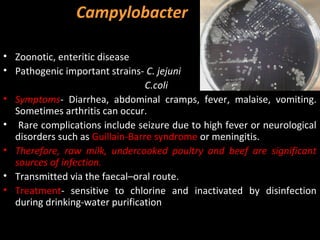
Campylobacter

• Zoonotic, enteritic disease
• Pathogenic important strains- C. jejuni
                                 C.coli
• Symptoms- Diarrhea, abdominal cramps, fever, malaise, vomiting.
  Sometimes arthritis can occur.
• Rare complications include seizure due to high fever or neurological
  disorders such as Guillain-Barre syndrome or meningitis.
• Therefore, raw milk, undercooked poultry and beef are significant
  sources of infection.
• Transmitted via the faecal–oral route.
• Treatment- sensitive to chlorine and inactivated by disinfection
  during drinking-water purification

Water borne diseases are acquired by drinking contaminated water or contact with contaminated recreational water. They account for 4.1% of global disease burden and 1.8 million deaths annually. Diseases are classified as water-washed, water-scarce, water-based, and vector-borne. Guidelines for safe drinking water include treating water through coagulation, sedimentation, filtration, and disinfection to remove pathogens and chemicals. Public education on water sources, treatment, and health risks is also important to prevent water borne diseases.